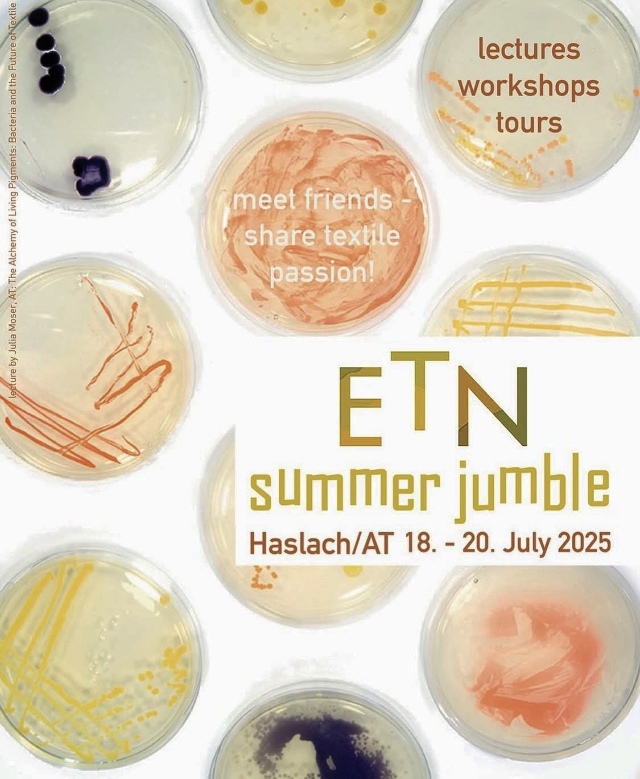
Bild

ETN Summer Jumble 2025
Veranstalter*in
Datum
- 18. Juli 2025–20. Juli 2025 Textiles Zentrum Haslach, Haslach an der Mühl, OO, Österreich
Text
The first ETN summer jumble will take place at the Textile Centre Haslach/Austria on the weekend of 18 - 20 July. This new format serves to bring the ETN community together for a personal exchange. Lectures and presentations on current work and research projects will alternate with hands-on sessions and mini-workshops in a relaxed atmosphere. In between, there will be time to enjoy the rural atmosphere of Haslach and become part of the Textile Kultur Haslach Summer Symposium, which takes place between 13 July and 1 August. In the week before and after the ETN meeting, a variety of workshops will be offered, with places reserved for ETN members: Renowned course leaders such as Tim Parry-Williams (GB), Daniel Henry (BE), Martine Gyselbrecht and Esther Van Schuylenbergh (BE), Kadi Pajupuu and Marilyn Piirsalu (EE), Maartje Bour (NL), Tanja Boukal (AT), Anita Bauer (AT), Magdalena Orland (DE) and many more, will be giving exciting workshops - an ideal opportunity to combine the ETN summer jumble weekend with a creative workshop week! In summer, the Textile Centre Haslach and the surrounding area will also be hosting a number of textile exhibitions and performances, as well as the International Weavers' Market on the weekend of 26/27 July. Reasons enough to make your way to Haslach!
Vortragende*r
Aktivitätenlisten
-
- Karin Altmann - Sprecher*in
-
Ort
Adresse
- Textiles Zentrum Haslach, Haslach an der Mühl, OO, Österreich
- Stahlmühle 4
- 4170 Haslach an der Mühl
- Österreich
Mediendateien
Bild#1
Bild#2
